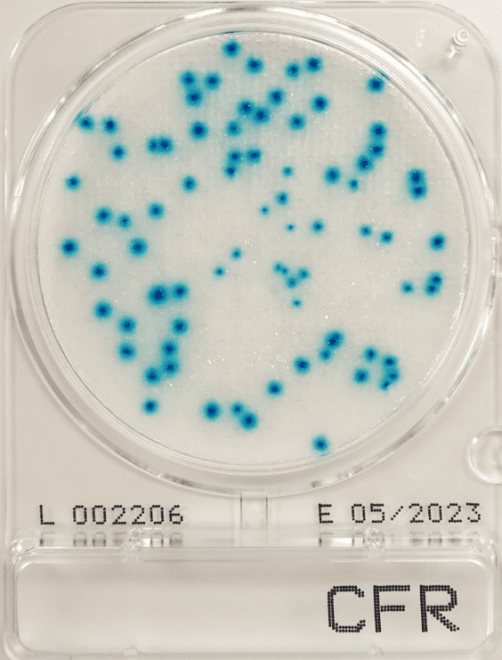
main product photo

Compact Dry CFR
Numer katalogowy
805-54070-CFR-1400
Producent
Opakowanie
40 szt., 240 szt., 1400 szt.
W magazynie
Płytki do detekcji coli kałowych i coli ogólnych.
Zaczynając od 329,21 zł 267,65 zł
Skontaktuj się z nami
Wpisz kod pocztowy, aby skontaktować się z najbliższym doradcą w Twoim regionie.
i Zdjęcie poglądowe produktu. Poszczególne warianty mogą różnić się od prezentowanego obrazu. Prosimy o zwracanie uwagi na cechy podane w tabeli/opisie.
| Opakowanie | Numer katalogowy | Dostępność | Cena brutto | Ilość | Operacja |
|---|---|---|---|---|---|
| 40 szt. | 805-54070-CFR-0040 | Brak w magazynie Produkt niedostępny w magazynie. | 329,21 zł | - + | |
| 240 szt. | 805-54070-CFR-0240 | Brak w magazynie Produkt niedostępny w magazynie. | 1 842,00 zł | - + | |
| 1400 szt. | 805-54070-CFR-1400 | Brak w magazynie Produkt niedostępny w magazynie. | 8 230,21 zł | - + |
Wszystkie produkty zostały pomyślnie dodane do koszyka.
i Zdjęcie poglądowe produktu. Poszczególne warianty mogą różnić się od prezentowanego obrazu. Prosimy o zwracanie uwagi na cechy podane w tabeli/opisie.
Compact Dry CFR to pożywka chromogenna przeznaczona do jednoczesnego wykrywania coli ogólnych i coli kałowych. Używana w analizach sanitarnych wody, produktów spożywczych i środowiska. Kolorie coli kałowych rozwijają się w określonym kolorze (zależnie od typu substratu); inne organizmy są hamowane. Spełnia wymagania norm dotyczących testów jakości wody i żywności.
Compact Dry CFR